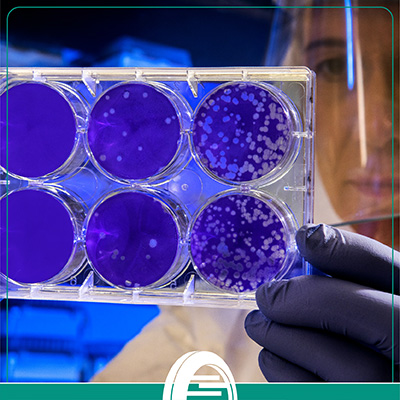

Veja abaixo os credenciamentos e habilitações que garantem a qualidade do nosso resultado.
- Laboratório Arkano certificado ISO/IEC 17025:2017
e credenciado junto ao MAPA para Anemia Infecciosa Equina e Mormo.
-
Laboratório Linhagen certificado ISO/IEC 17025:2017
e credenciado junto ao MAPA para paternidade Equina e Bovina.
-
Certificados de proficiência tanto nacional quanto internacional.